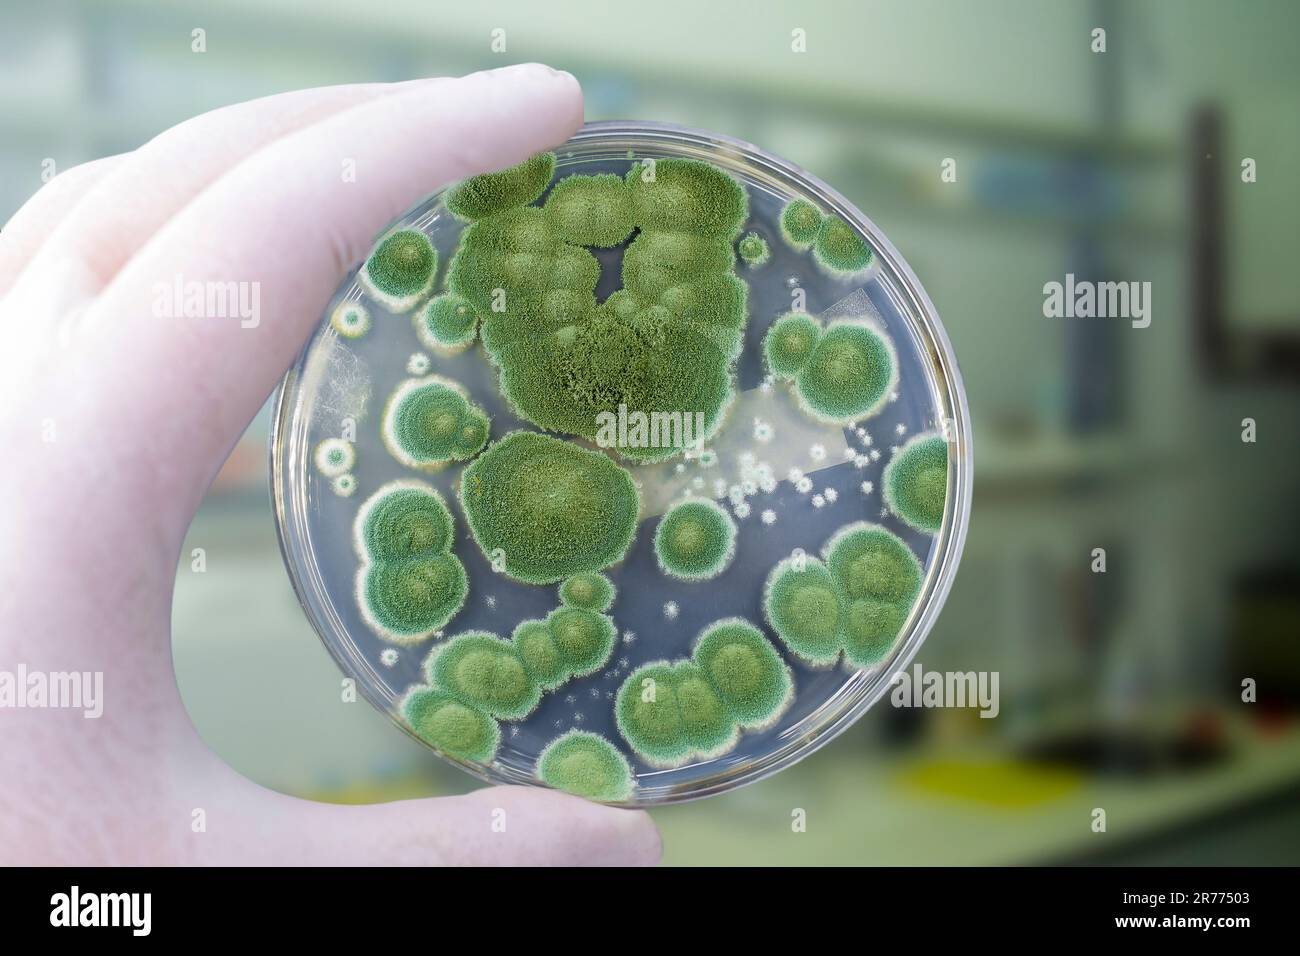
Researcher holding Petri dish with colonies of Penicillium fungi ...

Mold/fungus
Explore cultural diversity with our stunning Mold/fungus collection of countless multicultural images. celebrating diversity through photography, images, and pictures. perfect for cultural education and awareness. The Mold/fungus collection maintains consistent quality standards across all images. Suitable for various applications including web design, social media, personal projects, and digital content creation All Mold/fungus images are available in high resolution with professional-grade quality, optimized for both digital and print applications, and include comprehensive metadata for easy organization and usage. Discover the perfect Mold/fungus images to enhance your visual communication needs. The Mold/fungus archive serves professionals, educators, and creatives across diverse industries. Comprehensive tagging systems facilitate quick discovery of relevant Mold/fungus content. Professional licensing options accommodate both commercial and educational usage requirements. The Mold/fungus collection represents years of careful curation and professional standards. Cost-effective licensing makes professional Mold/fungus photography accessible to all budgets. Advanced search capabilities make finding the perfect Mold/fungus image effortless and efficient. Instant download capabilities enable immediate access to chosen Mold/fungus images. Time-saving browsing features help users locate ideal Mold/fungus images quickly. Multiple resolution options ensure optimal performance across different platforms and applications. Diverse style options within the Mold/fungus collection suit various aesthetic preferences.















































![Orange Slime Mold in Garden - Is it Dangerous? [2024] Guide](https://www.ultimatemoldcrew.ca/wp-content/uploads/2023/09/tree-wood-fungus-plasmodium-garden-spore-house-plant-soil-potted-plant-moss-wall-plasmodial-slime-cellular-slime-mushroom-fungus-growing.jpg)